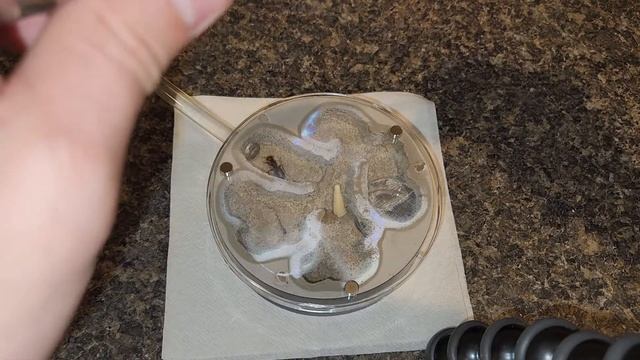
New Camponotus Pennsylvanicus Queen Home

Путешествия с медведем - Новые видео
-
-
Толиб Карими Озарахш - "Бегох шуд" -соли 1995 -طالب آذرخش در جواني
Шеъри Мавлоно Чалолиддин Руми, оханги устод Озарахш
Смотреть -
-
-
Everything Is Cheap // Super Sale // Haul Time Pinayaustralia
Big sale haul and super nice shopping.. Cotton on Typo Colette bags Thank you so much for watching Please don’t forget to subscribe,like and comm...
Смотреть -
-
-
Разбор бизнеса агенства недвижимости
Путь перемен с Ястребовым Алексеем. Разбор бизнеса по производству наклеек и стикеров. От Никиты. Записаться в телеграмм канал Пересборка: https://t.me...
Смотреть -
-
REACTING TO People CAUGHT CHEATING On CAMERA
These are the most dangerous jobs in the world, and today my friends and I are reacting to them! Comment the most dangerous jobs you can think of! WHAT...
Смотреть -
-
-
New Camponotus Pennsylvanicus Queen Home
Moving the new C. Penn Queen into her new home. Enjoy Need Ant Nectar or Liquid Feeders? https://amzn.to/3C4xrtW https://amzn.to/43zc4fW More Ant Stuff...
Смотреть -
23 жовтня — день працівників реклами | Живые открытки
Телеканал "Надія" вітає глядачів з днем працівників реклами 8 березня — Міжнародний день жінок https://youtu.be/791iYrYT-f8 3 березня — День письменн...
Смотреть -
Жителі ЖК “Синергія-2” вимушені виконувати роботу забудовника
Затиснуті у власному дворі, а тепер ще й залишилися без світла. Жителі комплексу “Синергія-2” запросили на зустріч представника Ірпінської міської ради....
Смотреть -
-
"La Campanella" Di Paganini - Performance Elsa Martignoni Violinist - Spot Kasanova
#Violino #Paganini #Kasanova Ecco lo spot dell'importante brand "KASANOVA utensili da cucina" sulle note del brano "La Campanella" di Paganini da me int...
Смотреть -
-
Cobra Kai: Daniel Is Demetri's Mister Miyagi
In this Cobra Kai video we discuss why, Daniel Is Demetri's Mister Miyagi. Get this video to 100 likes if you would like us to keep putting out more Co...
Смотреть -
Villa - Laska II
Artist: Villa Title Laska II Music and picture not by me. All credits belong to the artists. Playlist Available: Violin-ish: https://www.youtube.com/...
Смотреть